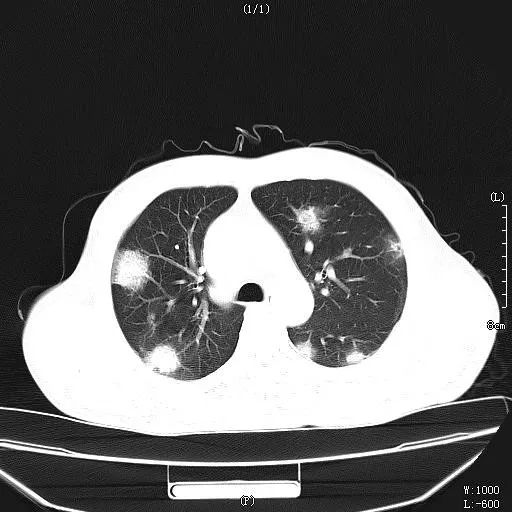
抗病毒治疗慢乙肝机制,慢性乙肝抗病毒治疗标准

作者:谭友文 江苏大学附属镇江三院
本文为作者授权医脉通发布,未经授权请勿转载。
病例分享
刘某,男,47岁,慢性乙肝,2016年曾因严重的慢性乙肝肝衰竭在我院治疗,经过当时努力抢救,获得新生,给予长期抗病毒药物恩替卡韦治疗,服用半年后,肝功能一直正常,HBV DNA也达到检测下限,虽然医生再三强调,抗病毒药物是长期治疗不能停药。

2016年肝功能

2017年底病毒学反跳
私自停用。2017年底,病毒学反跳,再次出现黄疸等症状,肝功能再次异常再次入院。经过抗病毒、保肝等治疗,病情控制,出院再三强调不得私自停用抗病毒药物。

但该患者,再次不遵守医嘱,2018年6月开始再次停用抗病毒药物,9月出现高度黄疸,恶心,呕吐等症状,肝功能急剧恶化,入院第3天出现肝昏迷,经过“人工肝”等治疗,病情一度好转,神志转清,但最终出现肺部“毛霉菌”感染,高热到40℃,最终多脏器衰竭死亡。
肺部感染病灶
慢性乙肝的治疗目的
慢性HBV感染的主要治疗目标是:通过预防疾病进展及后续HCC的发生,提高生存率及生活质量。抗病毒治疗的其它目标是:预防母婴垂直传播,乙肝病毒再激活,预防及治疗HBV相关肝外表现。
为什么要抗病毒?
HBV DNA复制水平是HBV感染特异性强、灵敏度高的指标,与慢性HBV感染的疾病进展、长期结局相关。通过抗病毒药物抑制病毒复制表明,绝大多数患者可以获得消除慢性HBV所致的坏死性炎症, 减轻进展期纤维化,降低HCC的风险。
HBsAg转阴
HBsAg消失被认为是理想的治疗终点,称之为“功能性治愈”,但是,目前的抗病毒治疗,罕见获得此目标。自发性HBsAg血清学转换,罕见出现炎性肝病再活动的情况,但是,对于免疫功能明显障碍的患者,则可出现肝炎再活动的情况。尽管目前治疗不能清除cccDNA 和已经与肝细胞整合的HBV DNA,但HBsAg的清除对患者安全停药和长期预后都有明显的益处,HBsAg清除后也要监测相关指标变化,这部分患者仍有发生HCC的风险 (年发病率大约为0.55%)。如果在年轻阶段获得HBsAg清除,和/或缺乏明显纤维化,则HCC的风险较低。
抗病毒策略
目前,慢性乙肝患者存在的主要治疗策略:采用核苷类似物或者干扰素α治疗。用于治疗乙肝病毒的核苷类似物包括:拉米夫定(LAM),阿德福韦酯(ADV),恩替卡韦(ETV),替比夫定(TBV),富马酸替诺福韦二吡呋酯(TDF)和艾拉酚胺替诺福韦酯(TAF);进一步分类为低耐药屏障抗HBV药物(LAM,ADV,TBV),以及高耐药屏障药物(ETV,TDF,TAF)。强力、高耐药屏障核苷类似物药物治疗的主要优势是:对于绝大多数患者,具有可预测的长期高效抗病毒作用,将HBV DNA抑制至不可测水平,以及安全性良好。这些药物可以安全用于任何HBV感染患者,而且可能是某些特定患者的唯一治疗策略,包括:失代偿期肝病、肝移植、肝外表现、急性乙肝或者慢性HBV严重恶化。
抗病毒的管理
对于需要治疗的患者,均可考虑予核苷类似物治疗,并选用高耐药屏障的药物,并且定期监测。基线时,应检测全血细胞计数,肝脏及肾脏功能(eGFR及血清磷),血清HBV DNA(采用高灵敏PCR测定)。
治疗期间,在治疗的第一年内,应每3~4个月检测肝脏功能,之后每6个月检测一次。治疗第1年内,每3~4个月检测HBV DNA,之后每6~12个月检测1次;如果HBV DNA不可测,则每12个月检测HBsAg定量,对于清除HBsAg的患者,应检测anti-HBs。长期核苷类似物治疗,应首选安全性较高的药物,尤其是年长的慢性乙肝人群,存在合并症的患者。
长期治疗可预见的结果
ETV或者TDF单药长期治疗表明可以阻止肝病进展,也可以明显改善坏死性炎症及纤维化,对于已经存在肝硬化的患者,通常可以缓解。而且,已经存在失代偿期肝硬化并发症的患者,尤其是失代偿早期,可以改善或者消除肝硬化,降低肝移植的需求。接受核苷类似物治疗的慢性乙肝患者,仍然存在进展至HCC的风险。